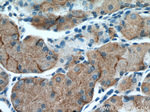
Leptin Antibody in Immunohistochemistry (Paraffin) (IHC (P))

Search
Proteintech
Leptin Polyclonal Antibody
{{$productOrderCtrl.translations['antibody.pdp.commerceCard.promotion.promotions']}}
{{$productOrderCtrl.translations['antibody.pdp.commerceCard.promotion.viewpromo']}}
{{$productOrderCtrl.translations['antibody.pdp.commerceCard.promotion.promocode']}}: {{promo.promoCode}} {{promo.promoTitle}} {{promo.promoDescription}}. {{$productOrderCtrl.translations['antibody.pdp.commerceCard.promotion.learnmore']}}
产品信息
17436-1-AP
种属反应
宿主/亚型
分类
类型
抗原
偶联物
形式
浓度
规格
纯化类型
保存液
内含物
保存条件
运输条件
产品详细信息
Immunogen sequence: MHWGTLCGF LWLWPYLFYV QAVPIQKVQD DTKTLIKTIV TRINDISHTQ SVSSKQKVTG LDFIPGLHPI LTLSKMDQTL AVYQQILTSM PSRNVIQISN DLENLRDLLH VLAFSKSCHL PWASGLETLD SLGGVLEASG YSTEVVALSR LQGSLQDMLW QLDLSPGC (1-167 aa encoded by BC060830)
靶标信息
Leptin is a 167 amino acid long protein hormone with important effects in regulating body weight, metabolism and reproductive function. Leptin is approximately 16 kDa in mass and encoded by the obese (ob) gene. Leptin is expressed predominantly by adipocytes, which fits with the idea that body weight is sensed as the total mass of fat in the body. Smaller amounts of leptin are also secreted by cells in the epithelium of the stomach and in the placenta. Leptin receptors are highly expressed in areas of the hypothalamus known to be important in regulating body weight, as well as in T lymphocytes and vascular endothelial cells. Leptin's effects on body weight are mediated through effects on hypothalamic centers that control feeding behavior and hunger, body temperature and energy expenditure. Leptin is involved in regulating food intake, energy expenditure, and adiposity through hypothalamic leptin receptors. Leptin promotes hematopoiesis, angiogenesis, wound healing, inflammation, immune responses, influences pubertal development and fetal growth. Studies have investigated the role of leptin in obesity, anorexia nervosa, insulin resistance, and hypertension. Leptin also has thermogenic actions and regulates enzymes of fatty acid oxidation. Severe hereditary obesity in rodents and humans can be caused by defects in leptin production.
仅用于科研。不用于诊断过程。未经明确授权不得转售。
生物信息学
蛋白别名: CD295 antigen; H-Leptin; HuB219; LEP-R; Leptin; leptin (murine obesity homolog); leptin (obesity homolog, mouse); ob; OB-R; obese; Obese protein; obese, mouse, homolog of; obesity; Obesity factor; obesity protein; unnamed protein product
基因别名: LEP; LEPD; OB; obese; OBS
UniProt ID: (Human) P41159, (Mouse) P41160
Entrez Gene ID: (Human) 3952, (Mouse) 16846